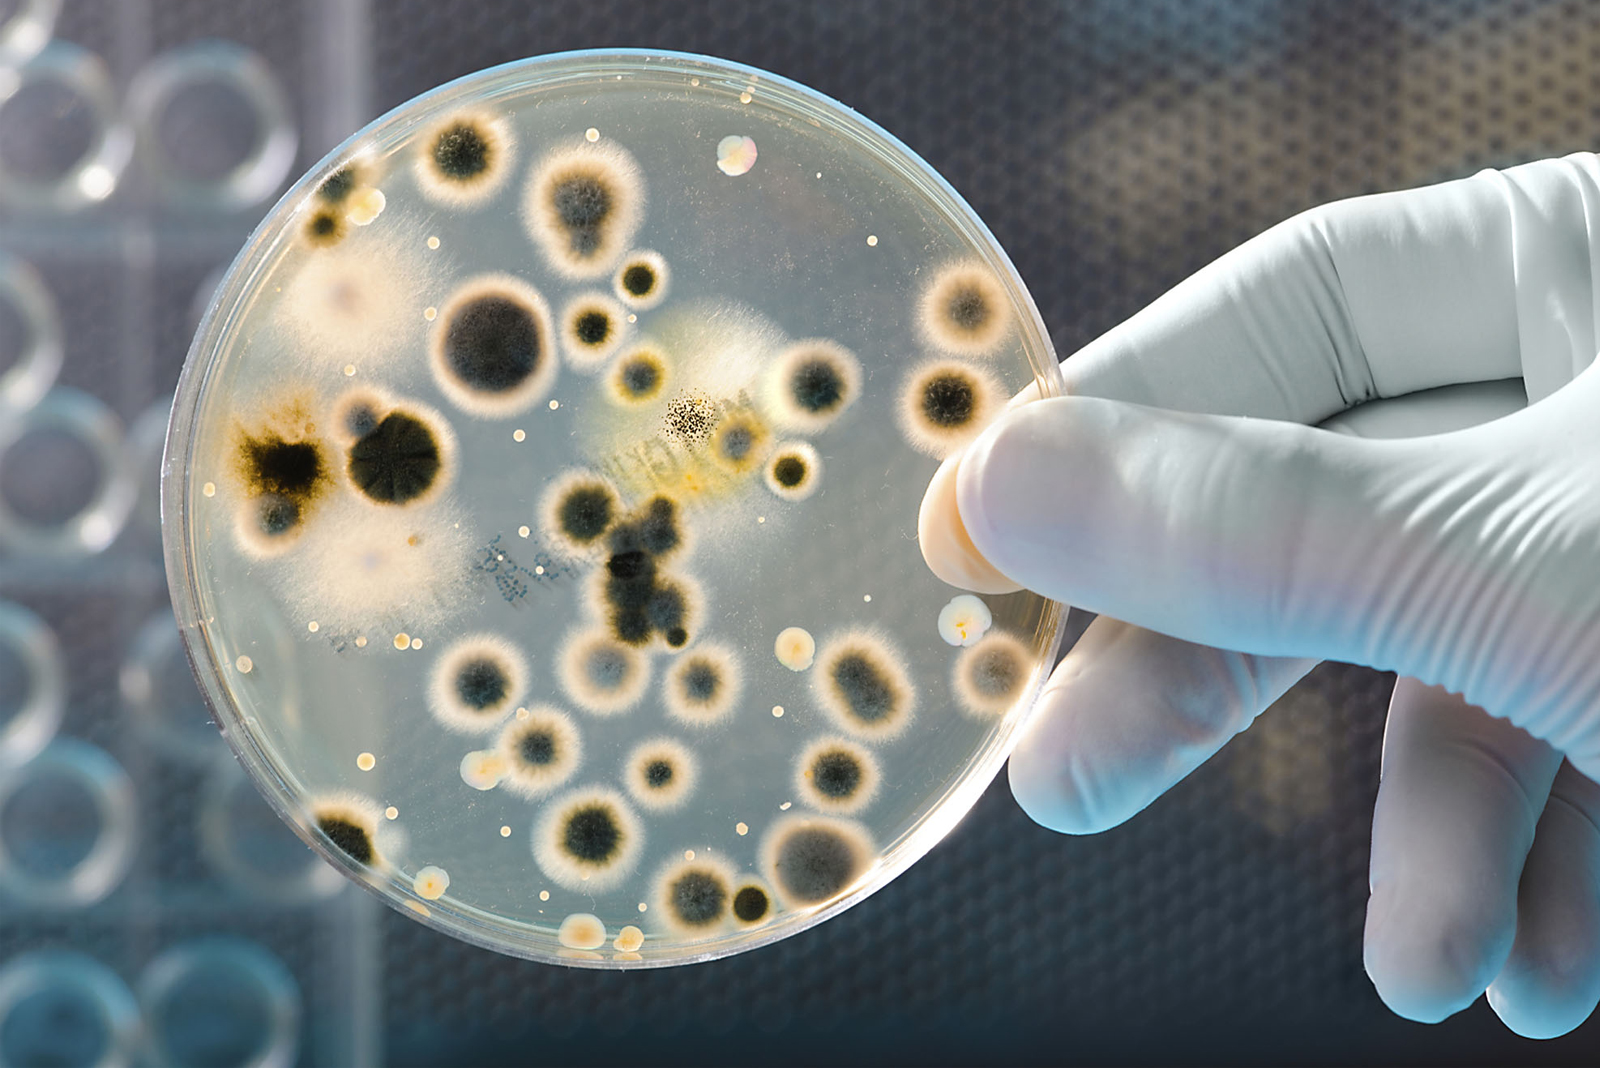

Getting people to understand how quickly bacteria can evolve antibiotic resistance might prevent the overuse of antibiotic drugs. Drug resistance is not some abstract threat. It’s real. See below.
Credit: Harvard Medical School
Getting people to understand how quickly bacteria can evolve antibiotic resistance might prevent the overuse of antibiotic drugs. Drug resistance is not some abstract threat. It’s real. See below.
Credit: Harvard Medical School